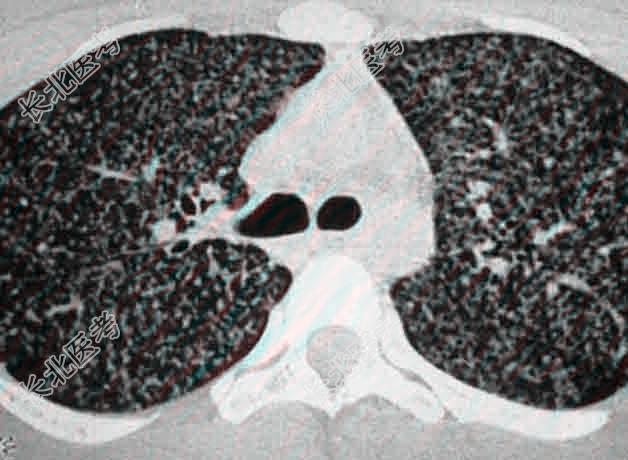

试题详情
- [材料题] 一名患有糖尿病的68岁妇女,因发烧.咳嗽.咯痰.气促20天而来诊。胸片示两肺散在性栗粒状.等大.均匀的病灶。痰检结核菌阴性,1:2000的OT(5TU)试验阴性,经一个月康结核药物强化治疗复查,病灶吸收好转。
- 多项选择题1.提示:胸部CT如图。
该患者的初步诊断考虑为
该患者的初步诊断考虑为 A、肺部感染
B、血行播散型肺结核
C、肺泡细胞癌
D、糖尿病
E、发热原因待查
F、陈旧型结核
关注下方微信公众号,搜题查看答案

- 多项选择题2.一般情况下,哪些患者会出现结核菌素试验阴性
A、未感染过结核
B、极度衰竭的结核病人
C、两周前刚接种过卡介苗
D、长期应用肾上腺皮质激素
E、肺结核病灶已纤维化或钙化
F、两月前曾接种过卡介苗
G、急性血行播散型肺结核
关注下方微信公众号,搜题查看答案

- 多项选择题3.本题干中的女性患者的OT试验阴性可能是:
A、不是肺结核
B、假阴性
C、老年人机体反应差
D、患有糖尿病并发严重急性血行播散型肺结核
E、她起病才20天,可能出于变态反应前期
F、肺结核病灶已纤维化或钙化
关注下方微信公众号,搜题查看答案

- 多项选择题4.患者入院后应完善相关哪些资料
A、详细追问有否结核病史及结核病的接触史
B、心肺等体格检查
C、胸部X片
D、胸部CT检查
E、痰结核菌培养
F、心电图
关注下方微信公众号,搜题查看答案

- 多项选择题5.根据机体免疫与变态反应的Koch现象,此病人最可能是:
A、初感染结核菌
B、再感染结核菌
C、尚未感染结核菌
D、曾接种过卡介苗,具有特异性免疫力
E、糖尿病并发肺部感染
F、糖尿病并发结核播散
关注下方微信公众号,搜题查看答案

- 多项选择题6.一般情况下,糖尿病合并结核病的胸片表现有如下特点:
A、以渗出干酪为主
B、可呈大块.巨块状
C、易形成空洞
D、易形成纤维钙化病灶
E、易合并血行播散型肺结核
F、病变进展快
关注下方微信公众号,搜题查看答案

热门试题
- 对于肺结核的中毒症状,使用糖皮质激素的方
- 慢性呼吸衰竭最常见的病因是A、重症肺结核
- 经皮细针抽吸确定病原体易引起哪些并发症A
- 卡介苗接种绝对禁忌证是A、PPD试验阳性
- 下列关于结核性胸腔积液特点的叙述,错误的
- 肺癌空洞、肺结核空洞、肺脓疡空洞最可靠的
- 1、最可能的诊断是A、左肺结核,右侧结核
- 急性胰腺炎发病早期最敏感的指标是(
- 早期非小细胞支气管肺癌最好的治疗方法是A
- 肺结核的基本病理变化中渗出为主的病变是指
- 1、为进一步明确诊断,该患应首先做的检查
- 女性,60岁, 慢性咳喘18年,近3年来
- 感染性胸膜炎最常见的病原菌是A、肺炎链球
- 嗅到花香味突然出现发作性咳嗽,离开即可减
- 男性,62岁。近5年来气急进行性加重。1
- 1、对此患者应予的处置包括2、查体:右上
- 1、此患者首先应做的检查是2、最可能的诊
- 男性,40岁。3年来反复咳嗽、咯血, 伴
- 肺炎发病率和病死率高的原因与下列哪些因素
- 肝酶(ALT)正常的肝病是A、药物性肝损